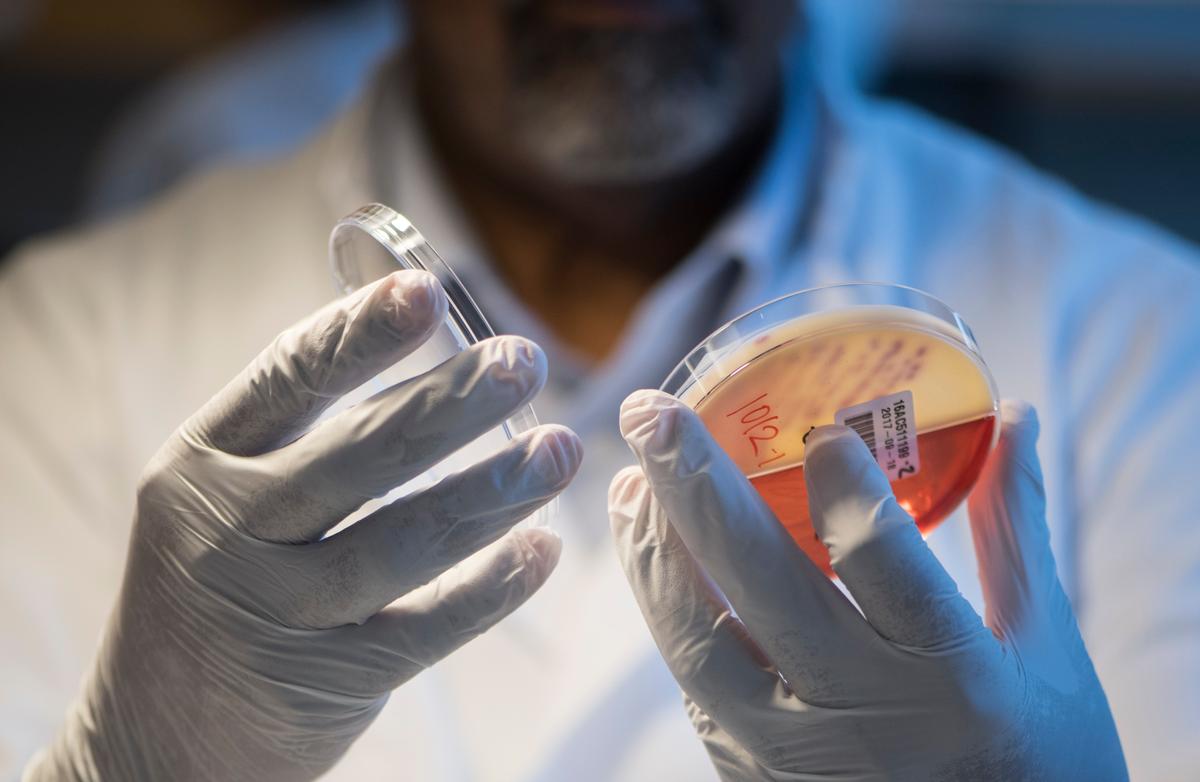

De skördar tusentals liv i Europa varje år. Multiresistenta bakterier är ett ökande hot – men nu har svenska forskare hittat en ny sorts antibiotika som visat sig lovande i djurstudier.

Nyheter
Mest läst i kategorin
Vi tror att det kan bli ett genombrott, säger professor Anders Karlén.
Det handlar om ett av de största hoten mot människors hälsa: Bakteriernas ökande motståndskraft, resistens, mot antibiotika.
Redan i dag beräknas resistenta bakterier skörda mer än 35 000 människoliv varje år inom EU/EES och behovet av nya effektiva antibiotika beskrivs som skriande.
Särskilt viktigt, men också särskilt svårt, är att hitta helt nya sorter i stället för varianter av gamla antibiotika. Detta för att minska risken för att bakterierna utvecklar resistens.
Och detta är just vad Uppsalaforskarna gjort.
Ovanligt att lyckas
Än så länge har den nya antibiotikatypen bara testats hos möss där den kunnat bota blodinfektioner, och mycket återstår innan fynden eventuellt kan utmynna i ett nytt läkemedel.
Men det är väldigt svårt att komma såhär långt och därför är vi glada att första steget ser lovande ut, säger Anders Karlén, som är professor vid institutionen för läkemedelskemi vid Uppsala universitet.
Antibiotikasorten riktar sig mot en bakterietyp som enligt Världshälsoorganisationen WHO är allra mest akut att få fram nya behandlingar mot.
Det handlar om så kallade gram-negativa bakterier som bildar enzymet ESBL, som bryter ner och förstör antibiotika.
Inget nytt på 50 år
Försöken i Uppsala, som redovisas i vetenskapstidskriften PNAS, visar på effekt mot två sådana bakterier, Escherichia coli och Klebsiella pneumoniae.
Det har inte kommit nya antibiotika mot gramnegativa bakterier sedan 1970-talet, så behovet är stort, säger Karlén.
Forskarna har undersökt mer än 400 olika molekyler innan de hittade den sort som tycks fungera. Den verkar genom att hämma ett protein som bakterien behöver för att tillverka sitt yttersta skyddslager.
Nästa steg är att förfina det potentiella läkemedlet och så småningom testa det på människor.
Det är svårt att få resurser till utveckling av nya antibiotika, men om allt går som vi vill hoppas vi kunna pröva det på människa om fem till sex år, säger Anders Karlén.









